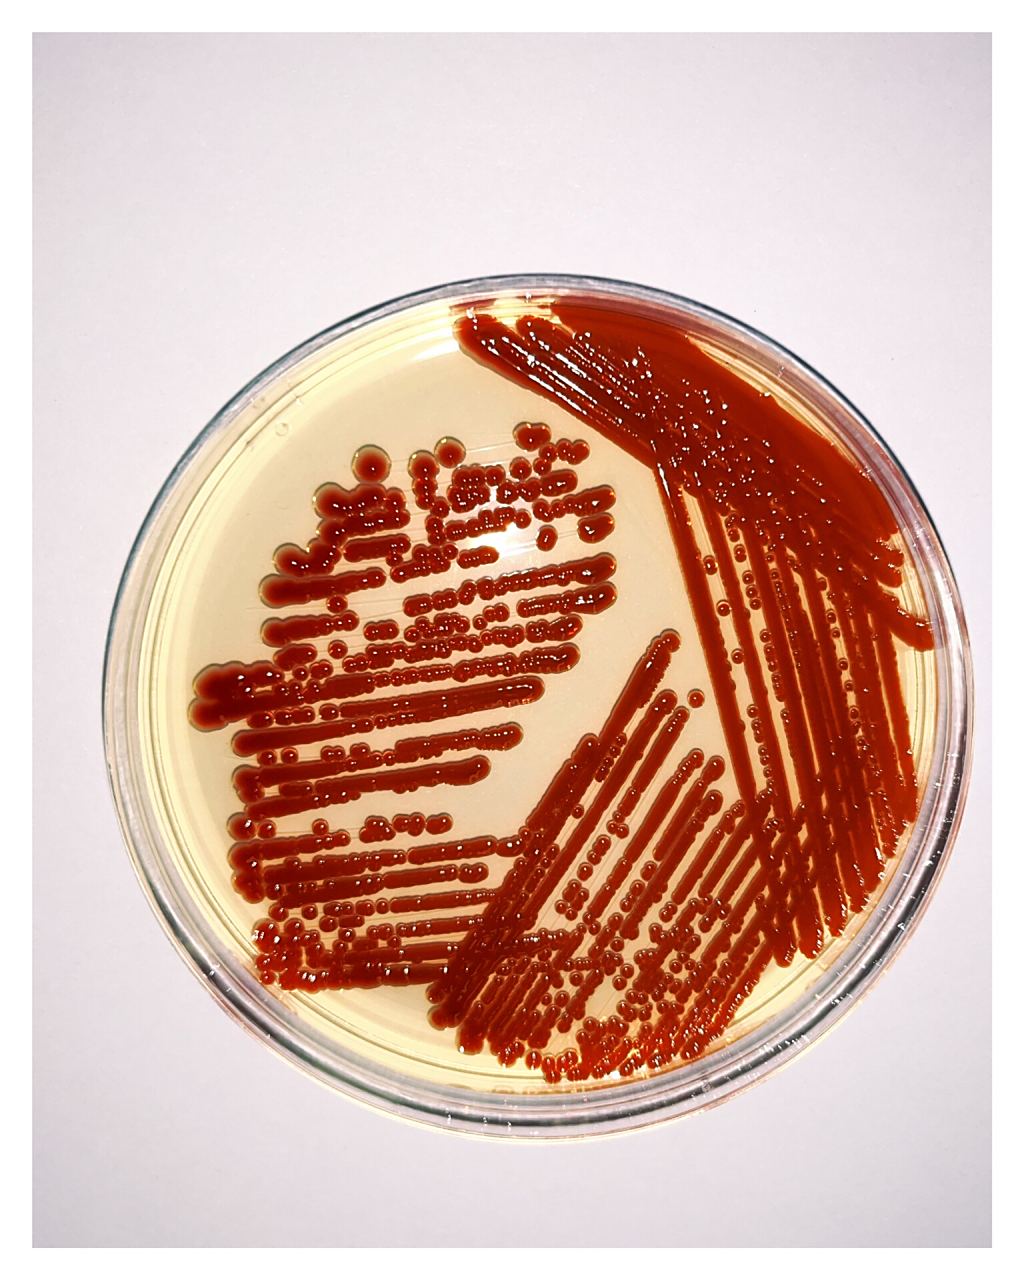
粘质沙雷氏菌
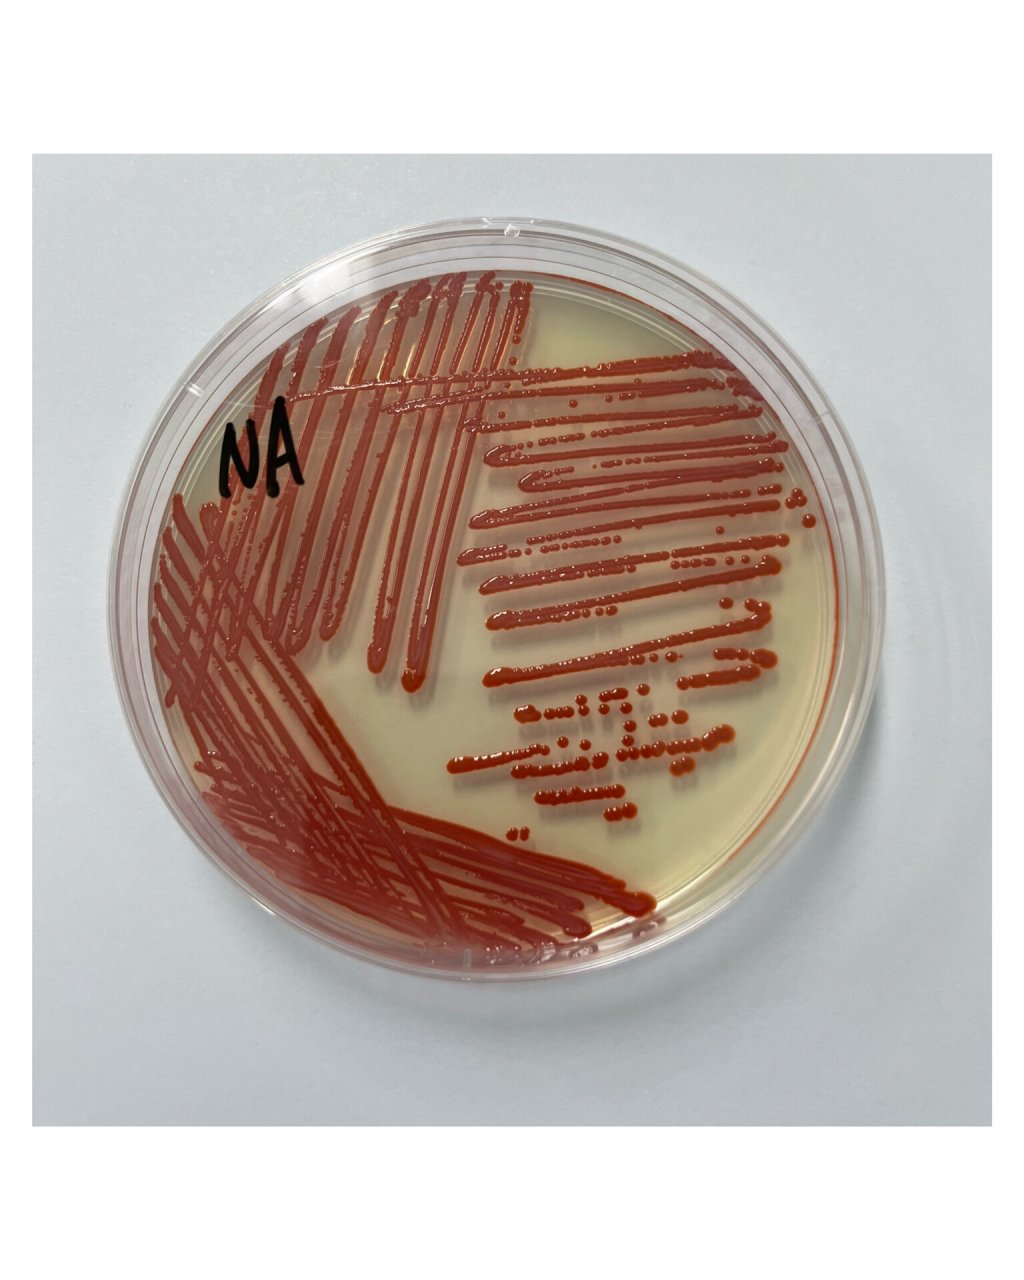
粘质沙雷氏菌
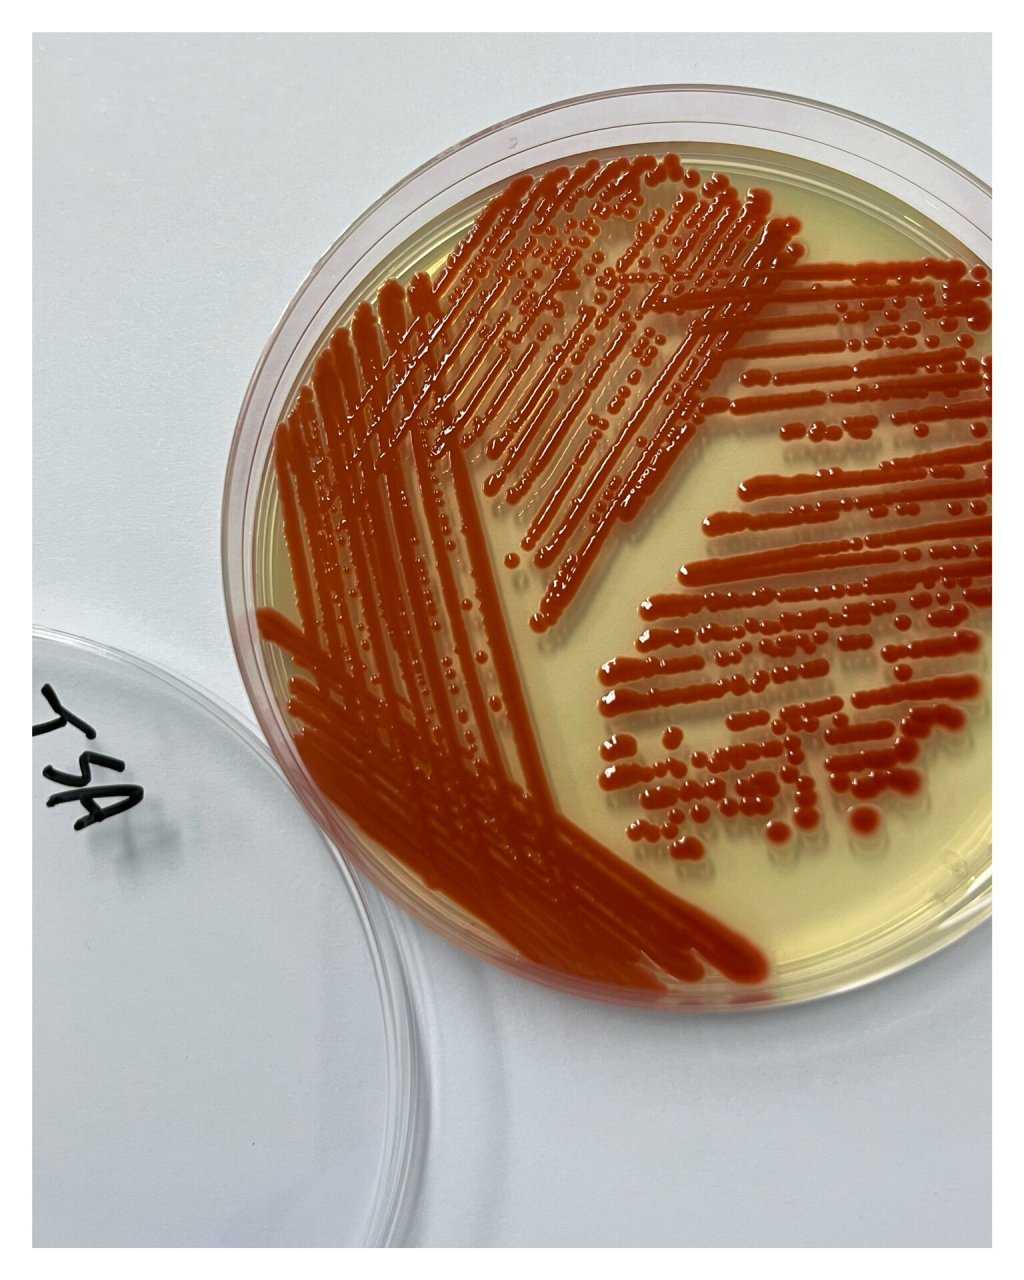
粘质沙雷氏菌

粘质沙雷氏菌

cn103981121a_一株粘质沙雷氏菌m9及其在去除重金属离子中的应用有效
图片尺寸432x432
粘质沙雷菌
图片尺寸640x601
粘质沙雷菌
图片尺寸1200x899
粘质沙雷氏菌(serratia marcescens)是一种杆状革兰氏阴性菌,属于实验
图片尺寸1200x800
粘质沙雷氏菌爱德华死后,医生将他感染"粘质沙雷氏菌"的事情报告给
图片尺寸640x551
生产灵菌红素的细菌,粘质沙雷氏菌,散布在琼脂平板上
图片尺寸1200x960
粘质沙雷菌是属于是什么菌?
图片尺寸300x353
粘质沙雷氏菌(serratia marcescens)是一种杆状革兰氏阴性菌,属于实验
图片尺寸1200x800
沙雷氏菌粘质细菌照片
图片尺寸450x300
粘质沙雷氏菌(serratia marcescens)是一种杆状革兰氏阴性菌,属于实验
图片尺寸1200x800
粘质沙雷菌菌落形态
图片尺寸497x373
粘质沙雷氏菌
图片尺寸1024x1280
粘质沙雷菌,皮氏培养皿,细菌,平衡折角灯,大群动物
图片尺寸1200x960
粘质沙雷氏菌
图片尺寸1024x1280
【黏菌】一毫米微小的大视野
图片尺寸2200x1332
粘质沙雷氏菌(serratia marcescens)是一种杆状革兰氏阴性菌,属于实验
图片尺寸1200x800
粘质沙雷氏菌(serratia marcescens)是一种杆状革兰氏阴性菌,属于实验
图片尺寸1200x800
p>沙门氏菌是一种常见的食源性致病菌.
图片尺寸600x480
粘质沙雷氏菌
图片尺寸1024x1280
介于真菌和动物之间的黏菌
图片尺寸550x651